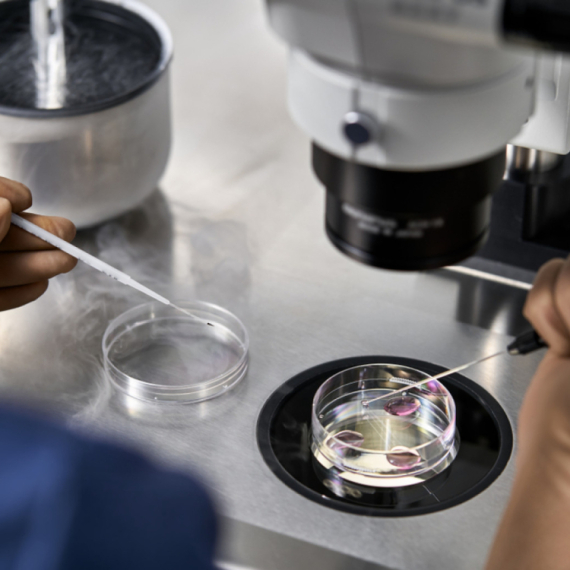

Značajne mogućnost: Vantelesna oplodnja u Srbiji i uz pomoć doniranih reproduktivnih materijala
Na vantelesnu oplodnju o trošku države i RFZO u toku prethodne godine poslato je 10.885 žena, a iz godine u godinu taj broj je sve veći.
16:00
9.4.2026.
82 d